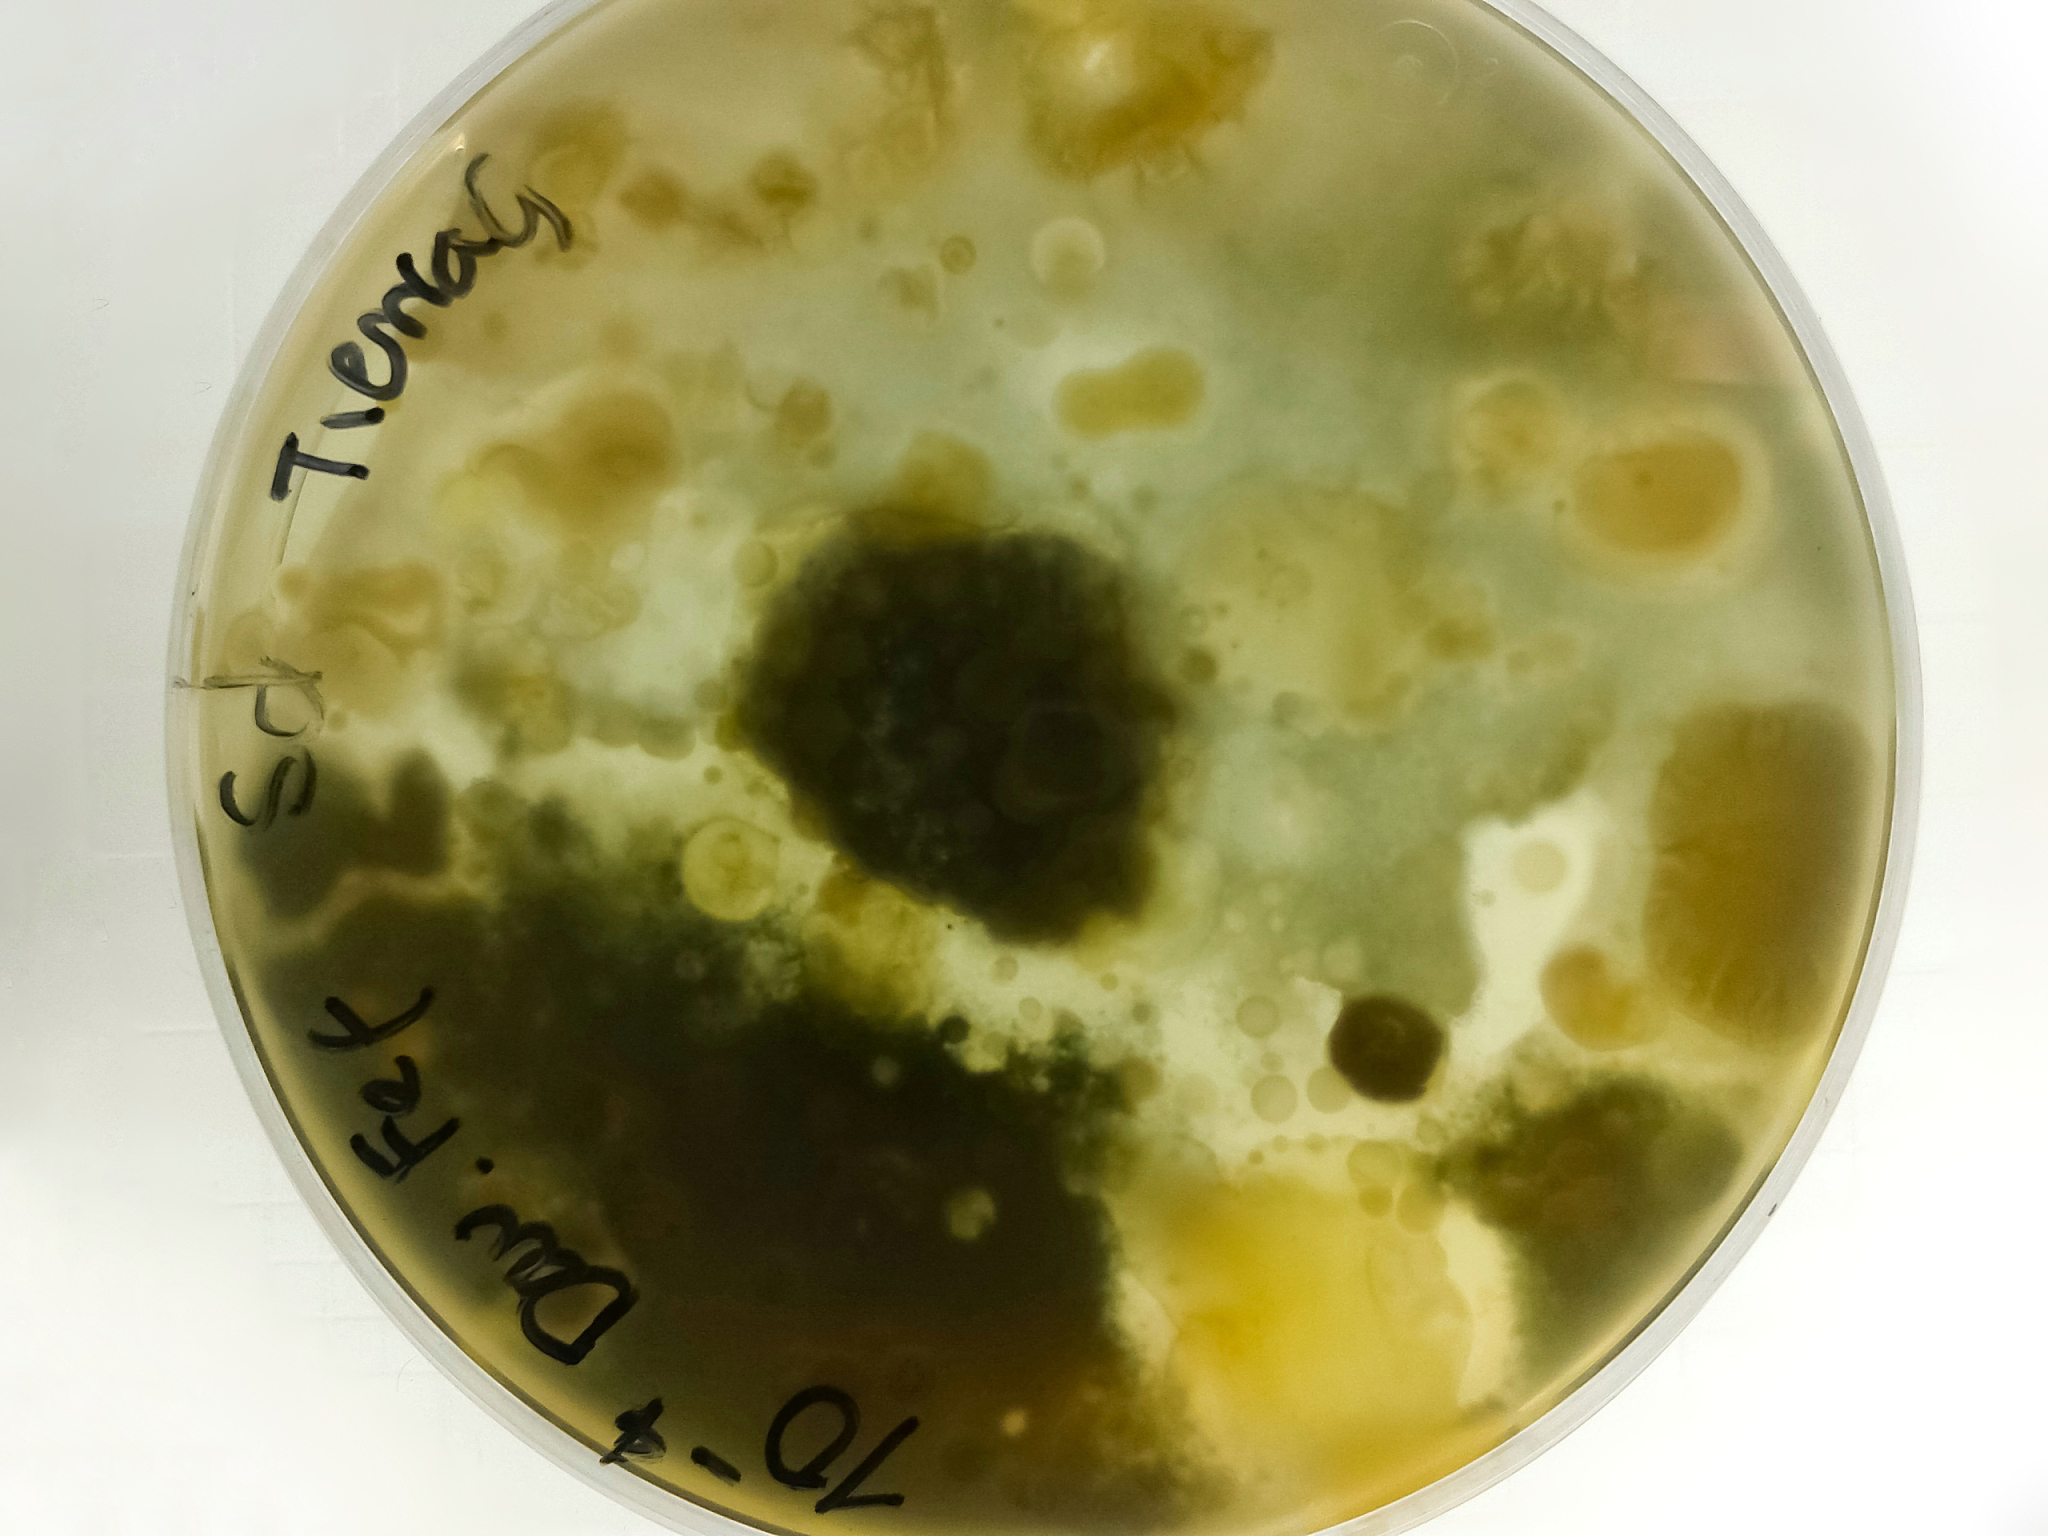
三年级最痛苦的拉肚子经历：轮状病毒、细菌感染、过期牛奶、发霉面包、贾第鞭毛虫

三年级最痛苦的拉肚子经历:轮状病毒、细菌感染、过期牛奶、发霉面包、贾第鞭毛虫
那是一个阳光明媚的春天,我正在上三年级。在这个年龄段,孩子们的身体抵抗力还比较弱,容易受到一些疾病的侵袭。而我,不幸地经历了几次拉肚子的折磨。
第一次拉肚子是因为轮状病毒感染。那天是体育课,我们正在操场上进行着跑步比赛。突然,我感到肚子有些不舒服,但时间紧迫,我没有来得及去厕所。结果,当我加速跑向终点时,肚子突然一阵剧痛,我不禁弯腰呻吟起来。同学们惊讶地看着我,老师也赶紧过来关心。我只能尴尬地告诉他们,我拉肚子了。这次拉肚子的症状非常明显,肚子疼痛,加上频繁的腹泻,使我非常难受。
第二次拉肚子是由于细菌感染。一天晚上,我喝了一瓶过期的牛奶,结果第二天早上起床时,我感到肚子有些不舒服。我去上学时,肚子一直在隐隐作痛,我不由自主地揉着肚子。到了上午的课间休息时,我突然感到肚子痛得厉害,难以忍受。我迅速跑向厕所,蹲在马桶上,肚子疼得剧烈抽动,我只能任由泪水流淌。这次拉肚子的症状是肚子剧痛,伴随着频繁的腹泻和恶心。
第三次拉肚子是因为吃了发霉的面包。那天早上,我匆忙地吃完早餐,没发现面包上有些微微的发霉。上午上课时,我感到肚子有些不舒服,但我没有太在意。然而,到了中午吃饭的时候,我突然感到肚子剧痛,我不得不放下手中的饭菜,快步走向厕所。刚一蹲下,肚子就剧痛起来,而且频繁的腹泻也不断困扰着我。这次拉肚子的症状是肚子痛得要命,伴随着频繁的腹泻和恶心。
第四次拉肚子是由于贾第鞭毛虫感染。那天,我去了一个农家乐,吃了一些没有煮熟的饭菜。晚上,我突然感到肚子不舒服,像是被什么东西刺激着一样。我躺在床上,卷曲着身体,肚子疼得让我无法入睡。第二天早上,我发现自己不仅肚子疼痛,还有频繁的腹泻和呕吐。这次拉肚子的症状是肚子刺痛,伴随着频繁的腹泻和呕吐。
通过这几次拉肚子的经历,我深刻地感受到了不同种类拉肚子的不同症状。轮状病毒感染导致肚子疼痛和频繁腹泻;细菌感染引起肚子剧痛、频繁腹泻和恶心;食用过期食品导致肚子痛得要命、频繁腹泻和恶心;贾第鞭毛虫感染则使肚子刺痛、频繁腹泻和呕吐。这些不同的症状提醒着我要注意饮食卫生,保护好自己的健康。
经历了几次拉肚子的折磨后,我更加懂得了健康的重要性。从那时起,我开始注重饮食卫生,保持良好的生活习惯,以免再次遭受拉肚子的痛苦。同时,我也明白了拉肚子对人的身体和心理都是一种折磨,我们应该时刻保持健康,远离各种疾病的侵袭。
原文地址: https://www.cveoy.top/t/topic/pUcJ 著作权归作者所有。请勿转载和采集!